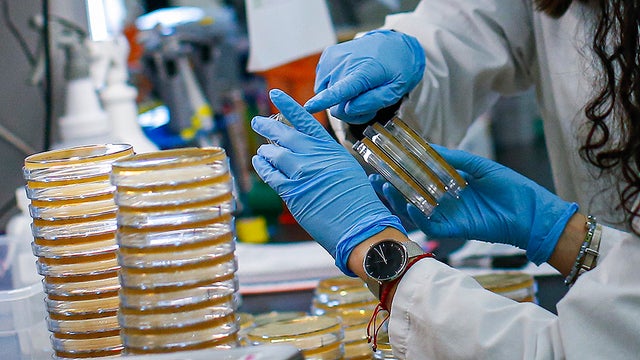
testing.jpg

Stephon Gilmore, James White Provide More Looks At Patriots' New Jerseys
Stephon Gilmore and James White, quarantined at home like most of America, shared some photos of the new Patriots jerseys on their Instagram pages on Monday.
Watch CBS News

Stephon Gilmore and James White, quarantined at home like most of America, shared some photos of the new Patriots jerseys on their Instagram pages on Monday.

It's the question on everyone's mind. How much longer are we going to be living like this?

An active-duty Boston Police officer died of coronavirus complications, the department confirmed Tuesday.

Doctors are finding that placing the sickest coronavirus patients on their stomachs -- called prone positioning - helps increase the amount of oxygen that's getting to their lungs.

Dr. Mallika Marshall says this is not the time to become complacent.

The T is projecting a $231 million budget deficit for the fiscal year that ends June 30.

A healthy 27-year-old Cambridge man is warning others that the coronavirus doesn't discriminate.

An 80-year-old woman was inside her Hanover home when a tree crashed through it.

The most important thing is to keep the fridge and freezer doors closed while power is out.

A group of nurses and respiratory therapists fighting coronavirus in Boston got a huge surprise from John Krasinski and David Ortiz.

Heavy rain, gusty wind and power outages are possible, especially for southeastern Massachusetts.
The total number of cases is now up to 25,475 with 756 deaths, according to the Department of Public Health.

Lynn is enforcing a 9 p.m. curfew, and both Lynn and Salem are requiring people to wear masks in public.

A Boston police captain can't thank the healthcare workers who kept him alive while he was suffering from COVID-19 enough.

Massachusetts health officials recommend people wear a mask or cover their face in public.

The Department of Public Health reported an increase of 2,033 coronavirus cases and 96 new deaths in Massachusetts Friday.

Salem, Massachusetts is taking a big step to help stop the spread of coronavirus in that city.

Gas prices continue to fall across the state, with averages now below $2 a gallon.

Will your children get April vacation? It depends on what school district you belong to.

The Boston Exhibition and Convention Center will soon be called "Boston Hope" a temporary coronavirus treatment hospital.

The Massachusetts Department of Public Health announced 70 new coronavirus deaths on Thursday. There are also 2,151 additional cases in the state.

Mass. Gov. Charlie Baker and Boston Mayor Marty Walsh both warned that coronavirus precautions may be in place for awhile.

Thunderstorms are possible with some being strong to severe with damaging winds, small hail, frequent lightning and heavy downpours.

All profits are going toward buying meals and supporting local small business employees.

These "porch portraits" show the bright side of being at home with family during coronavirus.

A prosecutor said Cole Werhan, the man charged with murdering a Duxbury, Massachusetts woman inside a Connecticut home, has several open domestic violence cases.

An Air Canada flight out of Newark, New Jersey was forced to divert and land at Boston's Logan Airport after the pilot became "incapacitated," Massachusetts State Police said.

There's a proposal in Cambridge to limit customers at bars and restaurants to one drink every 30 minutes.

A New Hampshire police department is looking for a man who allegedly stole a purse out of a car, and they say he looks like Chiefs tight Travis Kelce.

Boston Dynamics is expanding with a new robotics and AI center in Waltham, Massachusetts.

An Air Canada flight out of Newark, New Jersey was forced to divert and land at Boston's Logan Airport after the pilot became "incapacitated," Massachusetts State Police said.

There's a proposal in Cambridge to limit customers at bars and restaurants to one drink every 30 minutes.

Boston Dynamics is expanding with a new robotics and AI center in Waltham, Massachusetts.

A New Hampshire police department is looking for a man who allegedly stole a purse out of a car, and they say he looks like Chiefs tight Travis Kelce.

A man has been arrested for murder in connection with the death of Janina Brooke Murphy, months after she died in a Connecticut home.

Many people fear that a family history of dementia dooms them to inevitably suffer the condition themselves. But a new tool, the Brain Care Score, shows how lifestyle changes can be beneficial, cutting the risk of dementia.

There was a possible measles exposure at Logan Airport in Boston last week, Massachusetts health officials say.

A new study finds that a simple blood test could predict Alzheimer's disease long before symptoms appear.

The Lone Star tick, which can cause alpha-gal syndrome, is spreading north throughout Massachusetts.

Boston's cold and snowy winter might have an effect on this year's pollen allergy season.

A Massachusetts family thought their Vrbo stay would be protected after they had to cancel their trip to Hawaii due to severe weather. Now they're out $12,000.

A driver from Southboro, Massachusetts struggled for months to unravel a frustrating mix up with his E-ZPass account.

The gunman who allegedly opened fire on passing cars on Memorial Drive in Cambridge, Massachusetts is 46-year-old Tyler Brown from Boston.

There have been four violent attacks in three weeks at Tewksbury Hospital and a state representative is taking the fight to Beacon Hill to give security the non-lethal equipment back.

A family is demanding answers from the Gloucester, Massachusetts school district, after learning their five-year-old son was left alone in a quiet room for nearly half an hour.

Barney Frank, a Democrat who represented Massachusetts in Congress for 32 years, has died. He was 86 years old.

Both the Trump and Healey administrations are using government websites to blame each other for the shutdown.

Which party stands to take more of the blame from voters for the government shutdown? Here's what a new poll says.

A UNH Survey Center/Granite State poll shows John Sununu crushing Scott Brown by 23 points among likely primary voters in New Hampshire.

Seth Moulton said he's running against Sen. Ed Markey because "our party leaders are clinging to that old playbook."

There's a proposal in Cambridge to limit customers at bars and restaurants to one drink every 30 minutes.

Boston Dynamics is expanding with a new robotics and AI center in Waltham, Massachusetts.

Dozens of Boston bars and restaurants are taking advantage of a new Massachusetts law allowing for a later last call.

We now know when the sales tax holiday is coming to Massachusetts in August.

Gov. Maura Healey said Tuesday that she personally supports bringing back happy hour in Massachusetts.

Beauport, the Sleeper-McCann House has become one of New England's most imaginative seaside estates.

Blending clean modern lines with the warmth of a classic seaside retreat, this stunning North Shore coastal home was designed to feel both elevated and inviting.

Set across thirty acres of rolling lawns, wooded trails, and contemporary outdoor art, deCordova Sculpture Park and Museum invites visitors to experience art in the landscape.

James Beard Award-winning chef and restaurateur Karen Akunowicz has become known for her bold, Italian-inspired cooking and unmistakable culinary voice.

Just a short drive from Newport, the Norman Bird Sanctuary spans 300 acres of fields, forests, and coastal trails with sweeping views and more than six miles of hiking paths.

The Boston Celtics selected Chris Cenac Jr., a freshman forward/center out of Houston, with the 27th pick of the NBA Draft Tuesday night.

For now, Jaylen Brown is a member of the Boston Celtics.

The Boston Red Sox beat the Colorado Rockies 5-2 on Tuesday night.

The Washington Wizards selected Brockton native AJ Dybantsa with the No. 1 overall pick in the 2026 NBA Draft on Tuesday.

Rain jackets and ponchos were a common sight Tuesday, but the on-and-off showers did little to dampen the atmosphere at the FIFA Fan Festival on Boston's City Hall Plaza.

Haggis is not on the menu in Boston for the World Cup, despite what Gov. Healey told Scotland supporters in a lighthearted social media video.

There have been multiple sightings of a black bear in some unusual locations on the seacoast of New Hampshire and in southern Maine.

There's a smelly situation on the beach in Provincetown, Massachusetts after thousands of squid washed up on shore

Have you ever wondered where all the fish in the New England Aquarium come from? The answer is just down the road in Quincy.

Hopkinton, Massachusetts police are investigating video of a "suspicious" person walking into the middle of a road at night in front of a car.